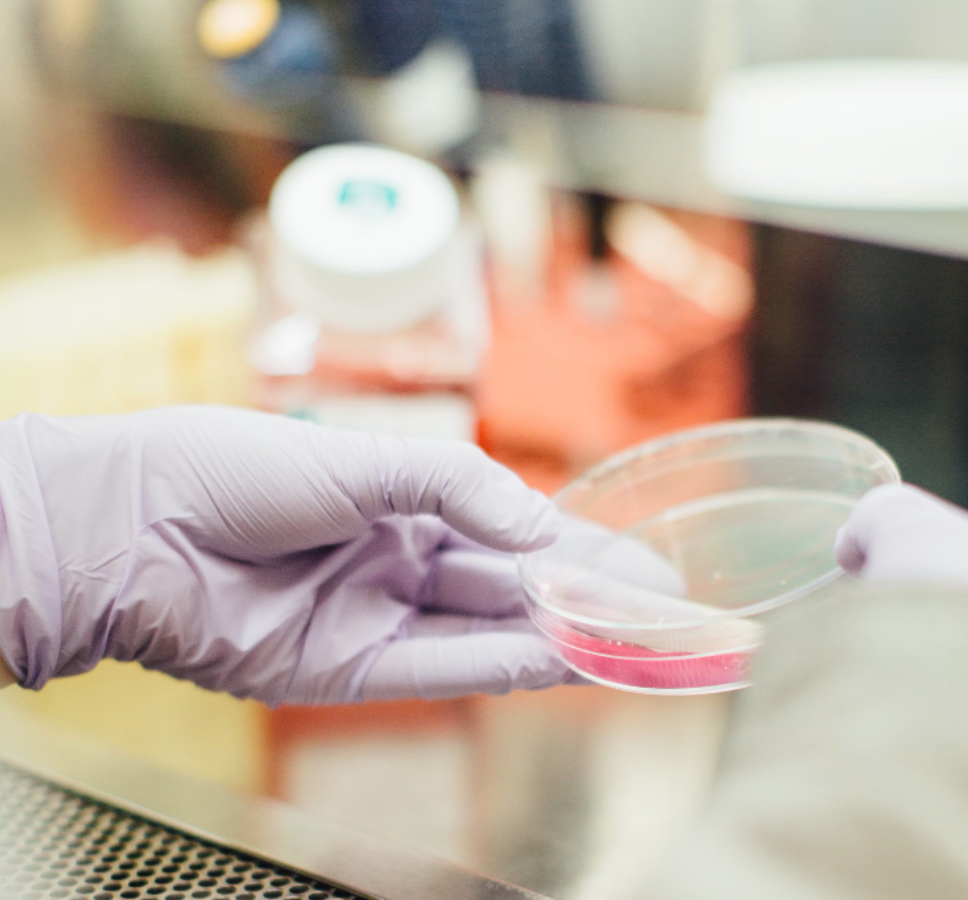
DNA Ancestry Kit

Finding gifts that say “thanks” can be tough, am I right? But having some go-to, uncommon thank you gift ideas makes showing appreciation less stressful. In 2025, there are many fun, unique ways to thank your peeps that put the “thought” in thoughtful gratitude giveaways. We’re talking the best unusual thank you gifts that’ll have your giftees grinning from ear to ear.
From personalized soy candles for the coworkers who make the office bearable to quirky popcorn variety packs for your BFF who loves movie nights, these employee gift ideas make saying thanks feel good. And who couldn’t use a little pick-me-up gift after hosting you for the holidays or helping you move? Yep, these thank you presents are guaranteed to spark joy for all the special people in your life.

How SwagMagic can help your brand?
- Bulk Buy & Save on your gifts!
- Curate Customized Swag Boxes!
- Launch Your Store for your employees!
- Secure Swag Storage with us!
Gifting should be fun, not lame! So we found the best thank you gift ideas that feature artisan spice blends, bath bombs, custom mugs, gift baskets filled with their fave treats, and even gifts for wine lovers like fancy bottles and customized wine glasses. Handmade and unique gifts are the move in 2025 – way better than some boring Starbucks card (no offense)! Anything to help spread a little more cheer and let those you care about know how much you appreciate them?
Table of contents
- Unusual Thank You Gift Baskets
- Unusual Thank You Gifts
- Popcorn Kernels for Movie Night
- Scented Candle
- Smart Mug
- Wine Glass
- Gourmet Gift for Foodies
- Handmade Greeting Card
- Thank You Ornament
- Soy Candle
- Seasoning Variety Pack
- Virtual Reality Painting Experience
- Star Naming and Interactive Sky Map
- Personalized Morse Code Jewelry
- DNA Ancestry Kit
- Floating Plant Pot
- Customized Comic Book
- Time Capsule Kit
- Bioluminescent Dino Pet
- Eco-Friendly Puzzle Furniture
- Voice-Activated Smart Plant Pot
- Personalized Star Map Quilt
- Bespoke Fragrance Blending Kit
- Cryptex Puzzle Gift Box
- Virtual Reality Travel Experience
- Glow-in-the-Dark Moon Clock
- Personalized Message in a Bottle
- Living Moss Wall Art
- Augmented Reality Artwork
- Personalized Constellation Globe
- Virtual Wildlife Safari Experience
- SwagMagic: Revolutionizing Global Gifting with Personalized and Unique Thank You Gifts
Unusual Thank You Gift Baskets
Thank You Snacks Gift Basket

When you want a thank you gift for friends, look no further than this gift basket brimming with swag and snacks. It includes a scented candle for relaxation, healthy snacks, and a heartfelt card conveying your gratitude. Thoughtfully curated, it’s the perfect way to wow your friend with a sincere thank you card.
Thank You Chocolate Bouquet
Curate the perfect box of handpicked gift they’ll love and send joy their way
Price: $104.00

Show gratitude with these artisan chocolate truffles in dark chocolate, milk chocolate, and white chocolate flavors. The gift box includes nuts, caramels, fruits, and creams – the perfect way to thank someone with a sweet tooth!
Spa Gift Set
Price: $60.00

Help friends relax with this self-care spa set! It includes a scented candle, bath bombs, a luxury eye mask, and exfoliating soap. After a long week, they can indulge in therapeutic me-time.
Wellness & Relaxation Box
Price: $12.50

Pamper your coworker with this self-care spa box! It’s packed with relaxing treats like a lavender eye mask, moisturizing lip mask, body butter, scented candle, and more. They’ll feel refreshed after enjoying these little luxuries.
Personal Wellness Thank You Gift Basket

A personalized thank-you gift she’ll adore, this basket overflows with a hand-picked appreciation gift. From the scented candle promoting self-care, a bottle of wine, thank you food gifts to the note conveying your gratitude, it’s the perfect way to say thanks and wow her with sincere appreciation.
Healthy Thank You Gift Box

For an uncommon good, this great gift box is the best gift idea for men. Filled with snacks for indulgence, thank you chocolate, and a sincere note of appreciation, it perfectly conveys your gratitude as a unique surprise.
Customized Swag Kit

Nothing goes better than a personalized branded swag kit. Opt for a curated kit with branded sweatshirts, customized hoodies, name-engraved cups, tech gadgets, and personalized office accessories when in doubt. This custom swag, being the cornerstone, is the perfect way to show your team they are valued and appreciated.
Unusual Thank You Gifts
Popcorn Kernels for Movie Night
Price: $32.00

Fresh-popped popcorn is the perfect snack for movie night at home. This set of 4 gourmet popcorn kernels in flavors like white cheddar and sea salt caramel will go the extra mile to satisfy their taste buds. It’s a thoughtful way to show your appreciation for any movie connoisseur.
Scented Candle
Price: $27.00

Help your coworker relax with this soy wax candle, covering calming scents like lavender and eucalyptus mint. It’s a perfect way to show your appreciation after a long workday. Nothing says “thank you” like the soft flicker and soothing scent filling their home decor.
Smart Mug
Price: $292.00

This smart mug also comes with an app to control the temperature of their drink, keeping it warm or cold as needed. It’s the perfect way to show appreciation, ensuring their coffee stays just right. Nothing says “thank you” like this modern piece of home decor for their desk.
Wine Glass
Price: $6.00

This gorgeous handblown wine glass is the perfect way to show appreciation for any wine connoisseur. It also comes in a set of 4, making it ideal for gatherings. Pair it with a bottle of cabernet or raspberry merlot, and they’ll be set for a Le Creuset-style dinner party!
Gourmet Gift for Foodies
For the foodie, this gourmet gift crate also includes aged balsamic vinegar, mixed nuts, and chocolate-covered espresso beans. It’s the perfect way to show your appreciation and satisfy their cravings in style. Nothing says “thank you” like a basket of delicious treats!
Handmade Greeting Card

This thoughtful, handmade card is the perfect way to show your appreciation through snail mail. The custom calligraphy and heartfelt message will go the extra mile, showing how much you care.
Thank You Ornament

Honor your teacher with this hand-painted ceramic ornament featuring a sweet “thank you” message. This thoughtful gift is the perfect way to show appreciation, adding a piece of decor to their holiday collection they’ll always remember.
Soy Candle
Price: $21.15

Help your teacher relax after long days in the classroom with this clean-burning soy wax candle. It comes in calming scents like lavender, eucalyptus mint, and cedarwood for a little aromatherapy at home. A Soy candle is a great thank you gift.
Seasoning Variety Pack
Price: $73.00

Spark culinary creativity with this spice set, including blends like lemon pepper and herbs de Provence. It’s a thoughtful way to show appreciation and inspire their home cooking.
Virtual Reality Painting Experience

Provide employees with a virtual reality painting kit to create art in a completely immersive digital environment. This is the perfect way to show your appreciation and go the extra mile by offering a unique and thoughtful thank you gift. It’s not just a creative outlet—it’s an experience they’ll cherish as a piece of decor in their virtual art gallery.
Star Naming and Interactive Sky Map

Allow employees to name a star and give them an interactive app to explore its location. Nothing says “thank you” like the gift of the cosmos! This thoughtful thank you gift is a perfect way to show your appreciation, blending both sentiment and curiosity. You may earn a commission recommending this unique, starry experience.
Personalized Morse Code Jewelry

Craft a piece of jewelry that features a hidden message encoded in Morse code, adding a mysterious and personalized touch. This elegant piece of decor they can wear is an ideal way to show your appreciation. The perfect way to go the extra mile, the jewelry also comes with a card explaining the encoded message, making it an Oprah-worthy keepsake.
DNA Ancestry Kit
Allow employees to uncover their ancestral origins and heritage through a DNA testing kit. It’s the perfect way to show how much you value their individuality. Employees can connect through this thoughtful gift, sharing their heritage stories in a way that encourages deeper relationships, just like Le Creuset cookware fosters bonds over shared meals.
Floating Plant Pot

Gift a levitating planter that hovers in the air through magnetic technology, adding an element of awe to their workspace. This unique planter is a perfect way to show your appreciation while incorporating a striking piece of home decor that sparks conversations. It’s more than just a planter—it’s an eco-friendly marvel of design that Oprah would love!
Customized Comic Book

Create a comic book that features the employee as the superhero, highlighting their achievements and contributions. It’s the perfect way to show you’ve gone the extra mile. This thoughtful thank you gift will also come with personalized illustrations and captions, making it a fun, one-of-a-kind keepsake they’ll treasure forever.
Time Capsule Kit

Provide a time capsule kit that employees can fill with personal mementos and bury to be opened in the future. Want to show your appreciation timelessly? This is the perfect thoughtful gift. The kit also covers instructions on preserving memories, making it a great way to say “thank you” while encouraging employees to reflect on their journey.
Bioluminescent Dino Pet

Gift a living bioluminescent pet that glows in the dark, introducing a touch of enchantment to its surroundings. This unique creature will become an engaging piece of home decor and a perfect way to show your appreciation and bring a little magic into their lives. It’s an extraordinary “thank you” gift that will be discussed long after the holiday season.
Eco-Friendly Puzzle Furniture

Provide a puzzle-like piece of eco-friendly furniture that employees can assemble, encouraging creativity and sustainability. Nothing says “thank you” quite like a functional and environmentally friendly gift. This is more than just furniture—it’s an interactive way to engage employees with decor they’ll build themselves.
Voice-Activated Smart Plant Pot

Give them a plant pot that responds to their voice and plays music or ambient sounds, creating a unique sensory experience. This voice-activated planter is a perfect way to show your appreciation. It also comes with built-in lighting, making it a stunning piece of home decor. The ideal thoughtful thank you gift, combining nature with smart technology!
Personalized Star Map Quilt

Craft a quilt that showcases a custom star map from a significant date, merging warmth and cosmic beauty. Nothing says “thank you” like a cozy throw blanket that tells a story. This is a thoughtful way to show your appreciation, with the quilt also doubling as a beautiful piece of decor for their home. Perfect for stargazing or snuggling up with a cup of Le Creuset cocoa!
Bespoke Fragrance Blending Kit

Offer a kit that allows clients to create their signature scent by blending various essential oils. A thoughtful thank you gift that goes the extra mile, the kit also covers fragrance tips for perfect blending. Whether they want to show off their scent to friends or enjoy the experience, this kit will surely spark joy.
Cryptex Puzzle Gift Box

Present a cryptic puzzle box that can only be opened by solving a series of codes or riddles, revealing the actual gift inside. Nothing says “thank you” quite like a challenge wrapped in mystery! The Cryptex box also comes with a customizable gift inside, making it an exciting and interactive way to show your appreciation.
Virtual Reality Travel Experience

Provide a VR headset that transports clients to exotic locations around the world. This immersive experience is a perfect way to show your appreciation and take them on adventures they never dreamed possible. It’s like gifting them a Le Creuset pot of cultural flavors without leaving their home!
Glow-in-the-Dark Moon Clock

Give a moon-shaped clock that glows in the dark and accurately displays the lunar phases. This beautiful piece of decor is not just a clock—it’s the perfect way to show your appreciation. The glow adds a touch of magic to any room, making it the ultimate thoughtful thank you gift.
Personalized Message in a Bottle

Send clients a message in a bottle with a heartfelt message or a customized scroll inside. This is the perfect way to show your appreciation with a touch of nostalgia. This thoughtful gift idea will go the extra mile, especially when the message also comes with a personal monogram or note.
Living Moss Wall Art

Present a piece of living moss wall art that adds a touch of nature and tranquility to their space. This thoughtful thank you gift is the perfect way to show your appreciation, combining a piece of home decor that grows with time. It’s like gifting a Zen garden for their wall!
Augmented Reality Artwork

Commission an augmented reality artwork that comes to life when viewed through a smartphone app. The perfect way to show your appreciation, this artwork also covers both traditional and digital art, making it an Oprah-worthy gift. When the piece comes alive, it will become the talk of their home decor!
Personalized Constellation Globe

Offer a globe that showcases constellations when illuminated, combining education and aesthetics. This thoughtful thank you gift is not just a globe, but also a beautiful piece of home decor. The illuminated constellations will inspire a sense of wonder every time they glance at it—just like when they see a Le Creuset pot bubbling with a hearty stew!
Virtual Wildlife Safari Experience

Arrange for clients to virtually explore wildlife reserves and encounter animals in their natural habitats. Want to show your appreciation with a wild adventure? This thoughtful gift idea will take them on a journey through nature. It’s the perfect way to show you care, and you may earn a commission when they rave about the experience to friends.
These unique gift ideas aim to capture the spirit of the “unusual” while expressing gratitude to employees and clients in distinctive and memorable ways.
In a world saturated with routine thank-you gifts, stepping out of the box with unusual gestures can make a difference. Your employees and clients will feel appreciated and valued for their distinct contributions. So, the next time you’re looking to express gratitude, consider these innovative and remarkable thank you gift ideas that will leave a mark long after the moment has passed.

SwagMagic: Revolutionizing Global Gifting with Personalized and Unique Thank You Gifts
At SwagMagic, we believe in making gifting more thoughtful and personal. Whether through custom swag store, curated gift boxes, or our print-on-demand services, we focus on creating memorable and unique gifts that stand out. From corporate gifts for events to personal celebrations, we’re here to help you find the perfect way to show your appreciation with truly special items.
We also care about the impact we make, which is why we use eco-friendly packaging and partner with local artisans to support sustainability. No matter the occasion, we’re dedicated to helping you express gratitude and build meaningful connections with gifts that leave a lasting impression. Book a call to create your own store.

